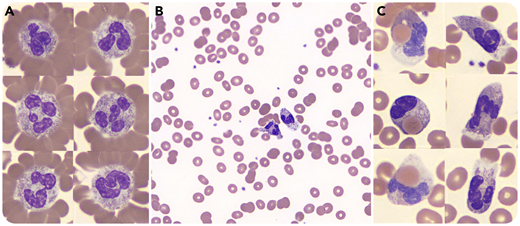
A 54-year-old man was admitted to the hospital with a 4-day history of progressive chills, lower-extremity myalgias, jaundice, and black urine. He had no significant medical history. Initial blood work showed hemoglobin level of 9.9 g/dL (reference range, 13.9-16.3 g/dL), total bilirubin of 7.7 mg/dL (reference range, 0.2-1.2 mg/dL), lactate dehydrogenase of 2204 U/L (reference range, 100-190 U/L), and ferritin of 41 291 ng/mL (reference range, 30-400 ng/mL). Review of the blood smear (Wright-Giemsa stain) showed neutrophil erythrocyte rosettes (panel A), erythrocyte couplets without overt agglutination (panel B), and active neutrophil erythrophagocytosis (panel C). Twelve hours postadmission, hemoglobin level fell to 7.0 g/dL; the patient received a transfusion, and methylprednisolone was initiated. During his admission, the patient continued to demonstrate active hemolysis, requiring transfusion of a total of 7 units of packed red blood cells. Direct antiglobulin test was positive for C3 and negative for immunoglobulin G. Cold agglutinin screen was negative. Donath-Landsteiner testing was positive for biphasic hemolysin, with hemolysis occurring at 37°C after incubation at 4°C, confirming the diagnosis of paroxysmal cold hemoglobinuria. An extensive infectious workup was negative, including for syphilis. On hospital day 6, the patient began to show signs of improvement, with decreasing lactate dehydrogenase, increasing hemoglobin, and downtrend in ferritin.

A 54-year-old man was admitted to the hospital with a 4-day history of progressive chills, lower-extremity myalgias, jaundice, and black urine. He had no significant medical history. Initial blood work showed hemoglobin level of 9.9 g/dL (reference range, 13.9-16.3 g/dL), total bilirubin of 7.7 mg/dL (reference range, 0.2-1.2 mg/dL), lactate dehydrogenase of 2204 U/L (reference range, 100-190 U/L), and ferritin of 41 291 ng/mL (reference range, 30-400 ng/mL). Review of the blood smear (Wright-Giemsa stain) showed neutrophil erythrocyte rosettes (panel A), erythrocyte couplets without overt agglutination (panel B), and active neutrophil erythrophagocytosis (panel C). Twelve hours postadmission, hemoglobin level fell to 7.0 g/dL; the patient received a transfusion, and methylprednisolone was initiated. During his admission, the patient continued to demonstrate active hemolysis, requiring transfusion of a total of 7 units of packed red blood cells. Direct antiglobulin test was positive for C3 and negative for immunoglobulin G. Cold agglutinin screen was negative. Donath-Landsteiner testing was positive for biphasic hemolysin, with hemolysis occurring at 37°C after incubation at 4°C, confirming the diagnosis of paroxysmal cold hemoglobinuria. An extensive infectious workup was negative, including for syphilis. On hospital day 6, the patient began to show signs of improvement, with decreasing lactate dehydrogenase, increasing hemoglobin, and downtrend in ferritin.
This case highlights the unique constellation of blood film findings that have high specificity, but low sensitivity, for paroxysmal cold hemoglobinuria, including neutrophil erythrocyte rosettes, erythrocyte couplets without overt agglutination, and active neutrophil erythrophagocytosis.
A 54-year-old man was admitted to the hospital with a 4-day history of progressive chills, lower-extremity myalgias, jaundice, and black urine. He had no significant medical history. Initial blood work showed hemoglobin level of 9.9 g/dL (reference range, 13.9-16.3 g/dL), total bilirubin of 7.7 mg/dL (reference range, 0.2-1.2 mg/dL), lactate dehydrogenase of 2204 U/L (reference range, 100-190 U/L), and ferritin of 41 291 ng/mL (reference range, 30-400 ng/mL). Review of the blood smear (Wright-Giemsa stain) showed neutrophil erythrocyte rosettes (panel A), erythrocyte couplets without overt agglutination (panel B), and active neutrophil erythrophagocytosis (panel C). Twelve hours postadmission, hemoglobin level fell to 7.0 g/dL; the patient received a transfusion, and methylprednisolone was initiated. During his admission, the patient continued to demonstrate active hemolysis, requiring transfusion of a total of 7 units of packed red blood cells. Direct antiglobulin test was positive for C3 and negative for immunoglobulin G. Cold agglutinin screen was negative. Donath-Landsteiner testing was positive for biphasic hemolysin, with hemolysis occurring at 37°C after incubation at 4°C, confirming the diagnosis of paroxysmal cold hemoglobinuria. An extensive infectious workup was negative, including for syphilis. On hospital day 6, the patient began to show signs of improvement, with decreasing lactate dehydrogenase, increasing hemoglobin, and downtrend in ferritin.
This case highlights the unique constellation of blood film findings that have high specificity, but low sensitivity, for paroxysmal cold hemoglobinuria, including neutrophil erythrocyte rosettes, erythrocyte couplets without overt agglutination, and active neutrophil erythrophagocytosis.
For additional images, visit the ASH Image Bank, a reference and teaching tool that is continually updated with new atlas and case study images. For more information, visit http://imagebank.hematology.org.
This feature is available to Subscribers Only
Sign In or Create an Account Close Modal